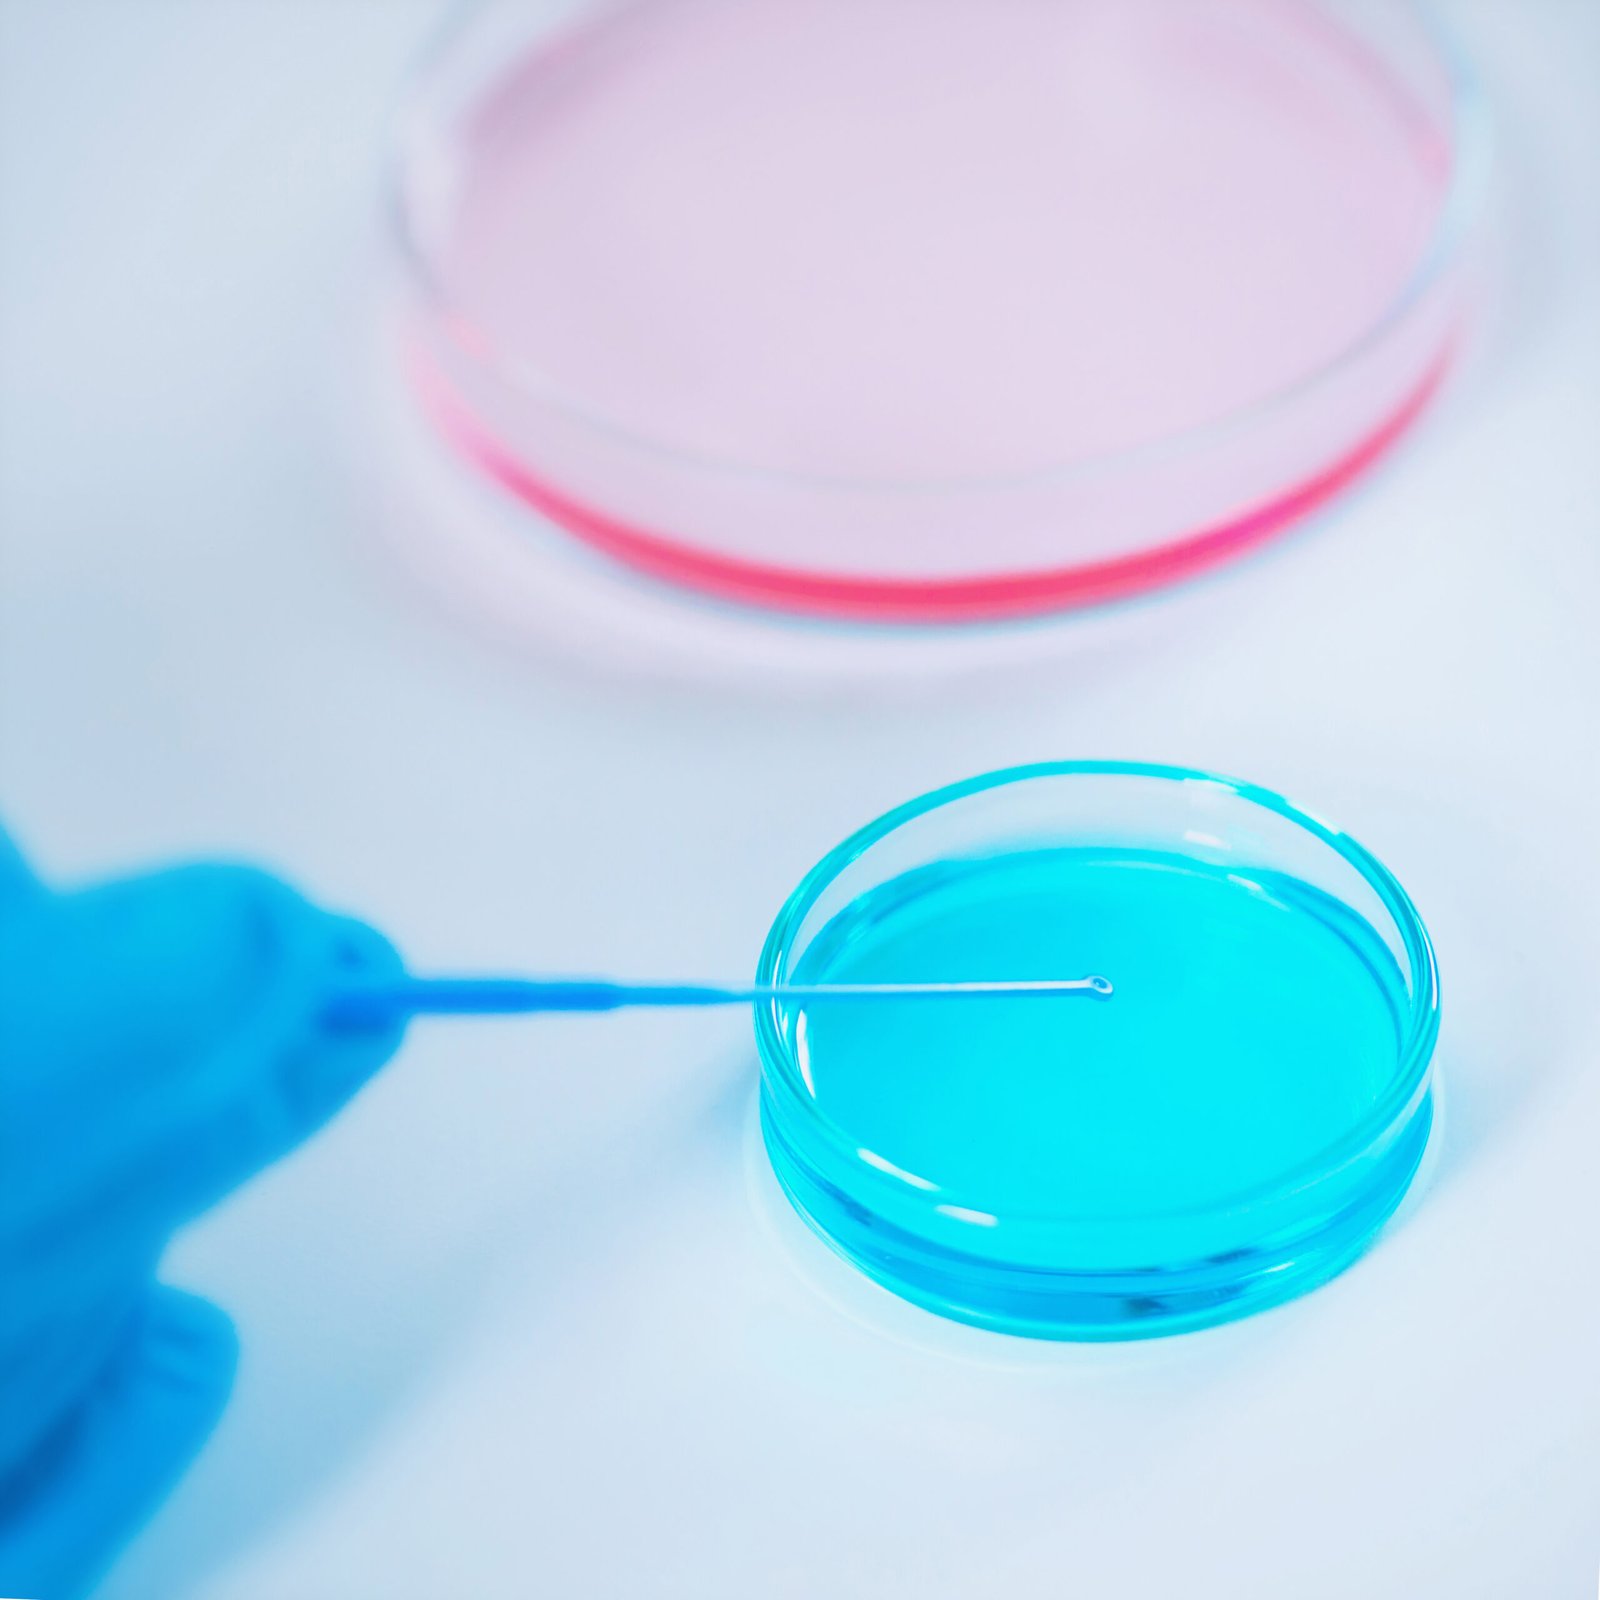

By choosing Kanhaa IVF Hospital for Donor & Cryopreservation services, you are partnering with a trusted provider in Udaipur, offering cutting-edge technology and compassionate care to help you achieve your dream of parenthood.
Donor & Cryopreservation
Healing Hands, Restoring Lives
Trusted Fertility Solutions with Kanhaa IVF Hospital and Dr. Nisha Agarwal
Donor Services & Cryopreservation in Udaipur
At Kanhaa IVF Hospital in Udaipur, under the expert guidance of Dr. Nisha Agarwal, we offer advanced Donor Services and Cryopreservation solutions to help individuals and couples achieve their dream of parenthood. Whether it’s through egg donation, sperm donation, embryo donation, or the freezing of eggs, sperm, and embryos for future use, we provide ethical, confidential, and compassionate care every step of the way. Our state-of-the-art fertility lab ensures the highest standards in preserving genetic material, giving hope to patients facing medical treatments, aging, or other fertility challenges. With personalized consultation, thorough evaluation, and world-class technology, Kanhaa IVF Hospital stands as a trusted center for Donor and Cryopreservation services in Udaipur.
At Kanhaa IVF Hospital in Udaipur, Dr. Nisha Agarwal leads a dedicated team in providing expert Donor Services (egg, sperm, and embryo donation) and advanced Cryopreservation (freezing of eggs, sperm, and embryos) to support patients on their fertility journey. Our focus is on maintaining the highest standards of safety, confidentiality, and ethical care. Whether you’re planning ahead for future family building, undergoing medical treatments, or facing fertility challenges, our tailored solutions offer hope and flexibility. With cutting-edge technology and compassionate counseling, Kanhaa IVF Hospital remains a trusted name for Donor and Cryopreservation services in Udaipur, helping dreams of parenthood come true.

Consultation for Donor & Cryopreservation Services at Kanhaa IVF Hospital, Udaipur
At Kanhaa IVF Hospital in Udaipur, we believe that the right guidance is the first step toward building your family. Under the expert care of Dr. Nisha Agarwal, we offer comprehensive consultation services for Donor Programs and Cryopreservation. Whether you are exploring egg donation, sperm donation, embryo donation, or planning to freeze your eggs, sperm, or embryos for future use, our consultations are designed to provide you with clear information, emotional support, and personalized treatment planning.
During your consultation at Kanhaa IVF Hospital, our team will thoroughly explain the available donor options, the entire cryopreservation process, legal and ethical considerations, success rates, and costs involved. We take the time to understand your unique medical and personal situation, ensuring that you make informed and confident decisions. Our compassionate and confidential approach has made us a preferred choice for Donor and Cryopreservation consultation services in Udaipur.
Book your consultation today with Kanhaa IVF Hospital and take your first step toward a future full of possibilities.
- Examination and Tests for Donor & Cryopreservation at Kanhaa IVF Hospital
At Kanhaa IVF Hospital, Udaipur, we ensure that every donor and recipient undergoes a thorough examination and testing process before proceeding with donor programs or cryopreservation. This careful evaluation is crucial to ensure the highest chances of success and the safety of both parties involved. Dr. Nisha Agarwal and our expert team follow stringent medical, genetic, and infectious disease screening protocols to maintain the highest standards of care and ethics.
Our detailed examination process includes a review of medical history, physical assessments, and a range of specialized fertility tests. For those opting for cryopreservation, the health and viability of eggs, sperm, or embryos are carefully assessed before freezing. Every step is designed to maximize success rates while safeguarding your future reproductive choices.
At Kanhaa IVF Hospital, Udaipur, our comprehensive examination and testing protocols for Donor and Cryopreservation services are designed to ensure the safety, success, and ethical integrity of every treatment. Led by Dr. Nisha Agarwal, we leave no stone unturned in offering the best care and building a strong foundation for your reproductive journey. Your health, hopes, and dreams are our priority.
Here are some of the check up and health screenings that you should get done:
- Blood Group and Rh Typing
- Infectious Disease Screening
- Hormonal Profile Testing
- Semen Analysis
- Genetic Carrier Screening
- Ultrasound Examination
- Karyotyping
- Pap Smear and Cervical Cultures
- Cryo-Survival Test (for sperm freezing)
Under the expert care of Dr. Nisha Agarwal, we provide detailed consultations to evaluate your unique situation and recommend tailored testing plans. Whether you are a donor or a recipient, our team ensures that you receive the right screenings—ranging from fertility evaluations to genetic and infectious disease testing—ensuring maximum safety and success.
- Concept of Donor & Cryopreservation at Kanhaa IVF Hospital, Udaipur
t Kanhaa IVF Hospital, Udaipur, we believe that every individual and couple deserves the chance to build a family, regardless of fertility challenges. Our Donor and Cryopreservation services are designed to offer hope, flexibility, and advanced reproductive options.
Donor services involve the use of donated eggs, sperm, or embryos from healthy and thoroughly screened individuals, helping those who are unable to conceive using their own gametes. It is a safe, ethical, and proven method for overcoming a wide range of fertility issues.
Cryopreservation refers to the advanced freezing and storage of eggs, sperm, or embryos for future use. This technology is vital for those who wish to preserve fertility before undergoing medical treatments like chemotherapy, facing age-related fertility decline, or planning for future family building.
Under the expert supervision of Dr. Nisha Agarwal, Kanhaa IVF Hospital offers state-of-the-art cryopreservation facilities, ensuring the highest standards of safety, security, and success.
With personalized care, ethical practices, and modern technology, we empower individuals and couples to take control of their reproductive future with confidence.
- Evaluation of Technology and Treatments in Donor & Cryopreservation
At Kanhaa IVF Hospital, Udaipur, we are committed to bringing the most advanced reproductive technologies to assist individuals and couples on their journey to parenthood. Our Donor and Cryopreservation services are backed by modern innovations in fertility science, ensuring high success rates, ethical standards, and complete patient safety.
Led by Dr. Nisha Agarwal, our team uses the latest diagnostic techniques and laboratory advancements to deliver precise evaluations, proper donor matching, and secure long-term storage through cryopreservation. We personalize every treatment plan based on patient needs, ensuring maximum comfort and care.
Evaluation
1. Evaluation of Donor Technology
At Kanhaa IVF Hospital, our donor program follows strict evaluation protocols. Donors are screened through comprehensive physical exams, genetic testing, infectious disease screening, and psychological assessments.
We ensure that only the healthiest and most suitable donors are selected, giving intended parents the best possible outcomes. Advanced matching tools are used to match donors based on physical attributes, ethnicity, and medical background to meet your personal preferences and health requirements.
2. Evaluation of Cryopreservation Technology
Our cryopreservation techniques involve cutting-edge vitrification (rapid freezing) methods for eggs, sperm, and embryos. This technology significantly improves survival rates during the thawing process, preserving the quality and viability of reproductive cells for future use.
We use highly secure storage systems with strict monitoring to maintain the safety and integrity of the preserved samples for years, offering peace of mind to individuals wanting to delay parenthood or safeguard fertility against medical conditions.
Treatment
1. Donor Treatment Options
Donor treatments at Kanhaa IVF Hospital include donor sperm insemination, donor egg IVF, and embryo donation. Based on your medical and fertility evaluation, Dr. Nisha Agarwal will guide you toward the most appropriate donor program that aligns with your dreams of building a family.
All treatments are carried out under ethical guidelines, with utmost transparency and support at every step.
2. Cryopreservation Treatment Options
Cryopreservation treatments involve freezing and future thawing of reproductive materials like eggs, sperm, or embryos. These options are especially beneficial for women delaying childbearing, cancer patients undergoing treatment, or couples undergoing IVF cycles.
Our team ensures that your preserved samples are ready for use whenever you are ready to start or expand your family — maintaining a high success rate during fertility procedures using cryopreserved material.
- Donor & Cryopreservation Services at Kanhaa IVF Hospital, Udaipur
At Kanhaa IVF Hospital in Udaipur, we offer comprehensive Donor & Cryopreservation services to help individuals and couples achieve their dreams of parenthood. Our state-of-the-art cryopreservation technology allows us to safely freeze and store eggs, sperm, and embryos for future use. Whether you’re looking to preserve fertility due to medical reasons or seeking donor sperm or eggs for IVF treatment, we provide expert evaluation and selection. Our services are tailored to meet your specific needs, ensuring the best chances of success with advanced technology and compassionate care. Trust Dr. Nisha Agarwal and our experienced team to guide you through every step of the process in a safe, ethical, and supportive environment.
- The Need for Donor & Cryopreservation Treatment at Kanhaa IVF Hospital, Udaipur
At Kanhaa IVF Hospital in Udaipur, we understand that every journey to parenthood is unique, and sometimes, medical or personal reasons require advanced fertility treatments. Donor & Cryopreservation services provide essential solutions for individuals and couples facing challenges with conception. Whether it’s due to age, health conditions, or infertility factors, these treatments offer a viable option for preserving fertility and increasing the chances of successful pregnancy in the future.
Types of Treatments Offered at Kanhaa IVF Hospital:
- Egg Cryopreservation
- Sperm Cryopreservation
- Embryo Cryopreservation
- Egg/Sperm Donation

Frequently Asked Questions
What is cryopreservation, and how does it work?
Cryopreservation is the process of freezing eggs, sperm, or embryos for future use. At Kanhaa IVF Hospital, we use advanced techniques to freeze and store reproductive cells, allowing you to preserve your fertility for later use, whether for medical reasons or personal choices.
Who might benefit from egg/sperm cryopreservation?
Egg and sperm cryopreservation are recommended for individuals who are planning to delay childbirth, undergoing medical treatments like chemotherapy that may affect fertility, or those with certain health conditions that may impact their reproductive abilities.
What are the What is the difference between egg cryopreservation and embryo cryopreservation?and side effects of treatment?
Egg cryopreservation involves freezing unfertilized eggs, while embryo cryopreservation involves freezing fertilized eggs (embryos). Embryo cryopreservation is generally recommended for couples undergoing IVF, while egg cryopreservation is ideal for women who may not be ready for pregnancy but want to preserve their fertility for later.
How do I choose a sperm or egg donor?
At Kanha IVF Hospital, we provide a thorough screening process for egg and sperm donors. Our team carefully selects donors based on medical history, genetic screening, and physical traits to ensure the highest standards of quality. We also offer anonymous and known donor options.
Is the process of freezing eggs or sperm safe?
Yes, cryopreservation is a safe and highly effective process. At Kanha IVF Hospital, we use advanced technology to freeze and store reproductive cells, ensuring their viability for future use. The process is closely monitored by our expert team to minimize any potential risks.
How long can frozen eggs, sperm, or embryos be stored?
Frozen reproductive cells can be safely stored for many years. The storage duration depends on the individual’s preferences and legal guidelines. At Kanha IVF Hospital, we offer long-term storage options and provide detailed guidance on managing storage.
Can I use cryopreserved eggs or sperm later in life?
Yes, cryopreserved eggs, sperm, and embryos can be thawed and used for fertility treatments such as IVF or IUI when you’re ready to start a family. This provides flexibility and convenience for those who wish to delay parenthood or are facing fertility challenges.
What is the success rate for IVF using frozen eggs or sperm?
The success rate for IVF using cryopreserved eggs or sperm depends on various factors, including the age and health of the donor or individual, as well as the quality of the frozen cells. At Kanha IVF Hospital, we provide personalized treatment plans and monitor each step closely to optimize success rates.
How do I get started with cryopreservation or donor services?
To get started with cryopreservation or donor services, schedule a consultation with one of our fertility specialists at Kanha IVF Hospital. Our team will guide you through the process, perform necessary screenings, and answer all your questions regarding the treatment options available to you.
Disclaimer: Results and patient experiences may vary. These are dependent on a number of factors including age, medical history, lifestyle and more.
